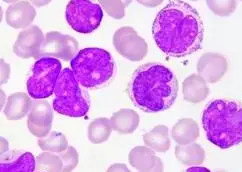
微信截图_20220427101524.png

Texas Red-LEL,TL;德州红®标记番茄凝集素(LEL,TL),Texas Red® labeled Lycopersicon Esculentum (Tomato) Lectin (LEL, TL)
深圳pg电子娱乐游戏app
怪物**供给一题材的凝集素;同一提供数据了很多荧光标志表达偶联的凝集素。提供数据了罗丹明、CY3、CY5、FITC、怪物素Biotin、琼脂糖Agarose、DyLight 488、DyLight 594、DyLight 649、Texas Red标志很多凝集素。凝集素(Lectin)是以另的一种从各个花草,无脊椎神经生物技术技术和高等专科学校生物技术技术中纯化的糖蛋清或通过实际糖的蛋清,因为能凝集红血球(含血型的物质),故名凝集素。实用的为花草凝集素(Phytoagglutin,PNA),一般而言故有被分离出的花草被命名,如刀豆素A(Conconvalina,ConA)、麦胚素(Wheat germ agglutinin,WGA)、生花生凝集素(Peanut agglutinin,PNA)和豆类凝集素(Soybean agglutinin,SBA)等,凝集素是这些食品的总称。凝集素可以有所作为另的一种探头来钻研组织细胞结构上特定的的糖基。同一因素面,凝集素含有多价通过实际力量,能与FITC荧光素、生物技术技术素、酶、橡胶胶体溶液部分金和铁蛋清等示踪物通过实际,为了在光镜与/或电镜品质表明其通过实际步位。一般而言主要采用荧光素、辣根过氧化的物酶、铁蛋清、橡胶胶体溶液部分金、Cyanine或生物技术技术素等对其去标注。 日前迄今为止荧光素异硫氰酸荧光素(fluorescein isothiocyanate,FITC)、辣根过脱色物酶和生物制品工程素符号凝集素的团队耐腐蚀复染。这段时间,pg电子娱乐游戏app
生物制品工程有限公司研发推出了Cyanine染剂符号的凝集素新产品的Cyanine Dye Conjugated Lectin。与过去的的荧光染剂基团好于,Cyanine染剂都具有更强的荧光,且荧光最好不要猝灭。这一Cyanine符号凝集素产品的的列装,为满足的凝集素用户账户带来了更多方面的决定区间。Cy3共轭物更易用帶有罗丹明(TRITC)油烟净化器器的荧光显微镜通过观察来做出考察。但Cy5共轭物常见运行装备有远红外光谱图三维成像的共聚交显微镜通过观察来来做出考察。这部分Cyanine标出的凝集素从而用以评定受损人体细胞和团体切块上的糖蛋白酶展示。该类的产品可大量适用以免疫检测荧光和流式的受损人体细胞实验英文中。番茄凝集素(Lycopersicon Esculentum (Tomato) Lectin , LEL/TL) 番茄凝集素(Lycopersicon Esculentum (Tomato) Lectin , LEL/TL)是由单*亚基组合的愈来愈安全稳定的糖淀粉酶,包含有50%阿拉伯糖和半乳糖,溶剂形态下易变成多聚体淀粉酶。或许番茄凝集素(Lycopersicon Esculentum (Tomato) Lectin , LEL/TL)与PL、DSL、WGA有着那部分雷同的特男人,并且在大多各方面番茄凝集素(Lycopersicon Esculentum (Tomato) Lectin , LEL/TL)展示出其特的地方。如番茄凝集素(Lycopersicon Esculentum (Tomato) Lectin , LEL/TL)可极好地与血型糖淀粉酶塔姆-霍斯福尔糖淀粉酶融合,虽然也能够用来标记符号啮齿哺乳动物毛细血管内皮组织细胞。

pg电子娱乐游戏app
微信公众号
官方微信